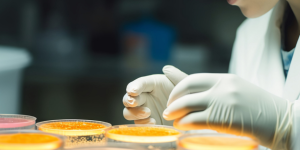
<?php the_title(); ?>

在波谲云诡的股市中,盲目投资如同在黑暗中摸索,不仅难以捕捉到真正的市场机会,还可能因决策失误而遭受重大损失。然而,随着点金财商股票分析软件的出现,这一切正在悄然改变。这款软件凭借其强大的分析功能和精准的市场洞察,正成为投资者精准捕捉市场机会的得力助手。
一、盲目投资的困境与挑战
在传统投资方式中,许多投资者往往依赖直觉、经验或小道消息进行决策,缺乏对市场全面、深入的了解。这种盲目投资不仅难以把握市场趋势,还容易受到情绪波动的影响,导致投资决策偏离理性。特别是在市场波动较大时,盲目投资往往会让投资者陷入被动,甚至遭受巨额亏损。添加QQ:1127261033(领取最新优惠)
二、点金财商股票分析软件的核心优势
1. 数据驱动,精准分析
点金财商股票分析软件采用先进的数据分析技术,对海量市场数据进行实时采集、处理和分析。通过多维度的数据模型,软件能够精准识别市场趋势、热点板块和个股潜力,为投资者提供科学、客观的投资建议。无论是短期波动还是长期趋势,软件都能通过数据揭示市场的真实面貌,帮助投资者做出明智的投资决策。
2. 智能预警,及时捕捉机会
软件内置智能预警系统,能够实时监控市场动态,并根据预设的条件自动触发预警。当市场出现重要变化或个股出现异动时,软件会立即向投资者发出提醒,确保投资者能够及时捕捉到市场机会。这种智能预警功能大大提高了投资者的决策效率,避免了因错过最佳时机而导致的损失。
3. 个性化推荐,量身定制策略
点金财商股票分析软件还具备个性化推荐功能,能够根据投资者的风险偏好、投资目标和市场环境,为其量身定制投资策略。无论是稳健型投资者还是激进型投资者,软件都能提供符合其需求的投资方案,帮助投资者在风险可控的前提下实现收益最大化。
三、点金财商股票分析软件的实际应用案例
案例一:精准捕捉板块轮动机会
在某次市场调整中,点金财商股票分析软件通过数据分析发现,科技板块即将迎来一波上涨行情。软件立即向投资者发出预警,并推荐了多只具有潜力的科技股。投资者根据软件的建议及时布局,最终在科技板块的上涨中获得了可观的收益。
案例二:及时规避个股风险
某只个股因公司基本面恶化而出现大幅下跌,点金财商股票分析软件通过智能预警系统及时捕捉到了这一风险,并向投资者发出了卖出建议。投资者根据软件的建议果断卖出,避免了进一步的损失。
四、结语
点金财商股票分析软件以其强大的分析功能、智能的预警系统和个性化的推荐策略,正成为投资者精准捕捉市场机会的利器。在未来的投资道路上,让我们告别盲目投资,拥抱点金财商股票分析软件,共同开启精准投资的新篇章!添加QQ:1127261033(领取最新优惠)。